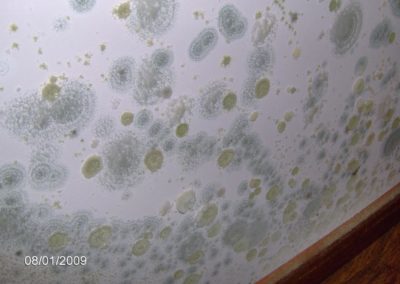
HPIM0526.JPG

Questa galleria di immagini mostra un vasto campionario di problemi di muffa.
Come si potrà vedere dalle immagini, le muffe possono essere circoscritte ad un angolo, oppure estese su una intera parete o anche più di una; possono essere di varie forme e persino conformarsi con delle condensazioni di acqua. Di tanto in tanto possono persino presentare una forma rotonda e orripilante alla vista.
Quando siamo in presenza di muffe estese o ricorrenti, il problema non può essere sottovalutato.